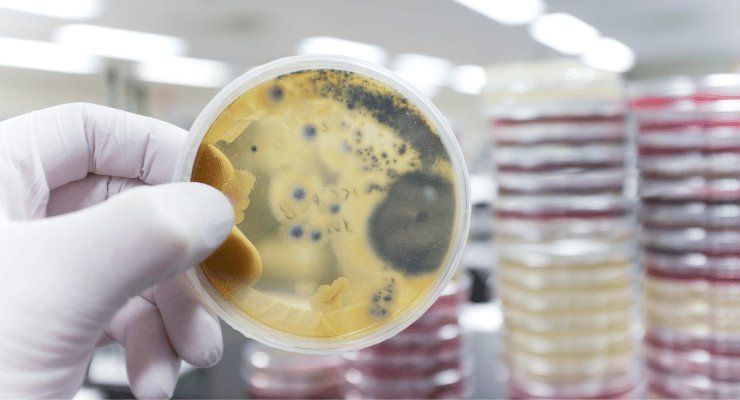

Dopo la notizia della morte di un uomo contagiato da Candida Auris a Milano, scopriamo cos’è questo fungo e quanto c’è da preoccuparsi.

Risale a poche ore fa la notizia della morte di un uomo contagiato da Candida Auris all’ospedale Sacco di Milano. L’uomo era stato ricoverato diversi giorni fa per un ictus, e le analisi di laboratorio avevano rivelato la sua positività al fungo patogeno. Secondo quanto riportato, il paziente deceduto aveva contratto l’infezione in Grecia. Ma cos’è la Candida Auris, e quanto è pericolosa?
Candida Auris, un fungo patogeno molto pericoloso
Non è un caso che la Candida Auris, che ha ucciso l’uomo ricoverato per ictus e morto all’ospedale Sacco di Milano, sia anche chiamata “il fungo killer”. Questo fungo patogeno, infatti, è pericolosamente infettivo.
Il contagio avviene generalmente per contatto con la pelle di soggetti infetti o con superfici contaminate. I sintomi che il fungo produce sono generici, motivo per cui è difficile da diagnosticare.
Comunque, finora il patogeno ha prodotto una mortalità che va dal 30% al 70%. Il fungo che provoca la Candida Auris ha la capacità di uccidere in circa 3 mesi soggetti fragili come anziani, neonati e pazienti con diverse patologie pregresse.
Un patogeno nella lista nera dell’OMS
Secondo i dati indicati dagli Annals of Internal Medicine, nel periodo che va dal 2019 al 2021 i casi di Candida Auris sono aumentati del 95%. Tra questi, i casi in cui il fungo ha mostrato resistenza ai farmaci in nostro possesso è aumentato di 3 volte.
Per questo, ad ottobre 2022 l’OMS ha aggiunto la Candida Auris alla lista di funghi patogeni con priorità alta. Il fungo è infatti un serio pericolo per la salute, proprio perché resiste alla maggior parte degli antimicotici somministrati ai pazienti che ne sono affetti.

Il primo isolamento della Candida Auris risale al 2009. In quell’anno, un campione prelevato dall’orecchio di una donna in Giappone risultò positivo a questo fungo. Da lì il nome Auris, che in latino significa orecchio. Tuttavia, non è nel 2009 che il fungo della Candida Auris ha fatto la sua prima comparsa. Tra alcuni campioni coreani è emerso infatti una prima traccia di questo fungo risalente al 1996.
In Europa, la Candida Auris è arrivata nel 2015, con alcuni focolai. Ma è soltanto nel 2019 che nel nostro Paese si è parlato per la prima volta di infezione invasiva da Candida Auris. E quel primo caso ha innescato un focolaio poi estesosi in alcune regioni del Nord Italia, particolarmente in Liguria. Focolaio che ha interessato il biennio 2020-2021, nel pieno della pandemia da Covid-19.
Mortalità, resistenza e contagio da Candida Auris
Un altro fattore preoccupante del fungo patogeno in questione è l’elevata mortalità che gli esperti hanno riscontrato nei casi di infezione. Si tratta di un tasso di mortalità che oscilla tra il 30% e il 70%.
Ciò è dovuto al fatto che il fungo resiste alla maggior parte dei farmaci antifungini in circolazione, in particolare alla classe delle echinocandine. Questo fa sì che, in mancanza di una terapia tempestiva e adeguata, il fungo provochi infezioni davvero gravi, specialmente nei soggetti con patologie pregresse.
Altro fattore a cui prestare attenzione è l’elevata contagiosità del fungo da Candida Auris. La malattia si trasmette tramite contatto con superfici contaminate e persone infette. A renderlo particolarmente pericoloso è il fatto che il fungo è in grado vivere a lungo colonizzando le superfici, inclusa la nostra pelle, per diversi mesi. Ed eliminarlo è davvero difficoltoso, in quanto resiste ai comuni antisettici.
Perché è in grado di farlo? La ragione sta nella riproduzione di questo fungo, che avviene per ricombinazione. Ciò vuol dire che quando il fungo si riproduce cambia aspetto, producendo una nuova variante. E questo fa si che dall’unione di due ceppi resistenti ad antimicotici diversi nascerà una nuova variante resistente ad entrambi i farmaci, e per questo più forte e pericolosa.
Un’emergenza da non sottovalutare
L’esperienza insegna, e questa è la domanda che tutti ci stiamo ponendo: siamo davanti al nuovo Covid-19? Non è il caso di creare allarmismi, ma la Candida Auris non è una minaccia da sottovalutare, in quanto può potenzialmente causare epidemie negli stessi ospedali, visto che permane a lungo sulle superfici. E i comuni disinfettanti poco possono fare davanti a tanta resistenza.
In più, non è semplice neanche effettuare una diagnosi tempestiva dell’infezione, in quanto per riconoscerla sono necessari esami di fluidi corporei, ad esempio la coltura del sangue. E anche in caso di disponibilità di esami del genere, il rischio è quello di confondere facilmente questo patogeno con altre tipologie di Candida. Per questo, è necessaria una strumentazione specifica per produrre una diagnosi certa.
E non si può neanche fare affidamento sui sintomi, in quanto sono generici e non particolarmente riconducibili a questo virus. Inoltre, i pazienti generalmente contagiati dal fungo patogeno presentano già diverse altre malattie, motivo per cui tali sintomi potrebbero essere confusi.
Questo fa sì che un paziente potrebbe essere positivo alla Candida Auris anche senza sintomi per lungo tempo, per poi manifestare i sintomi di una patologia invasiva nel momento in cui le sue difese immunitarie si abbassano.

Comunque, secondo l’ISS, i principali sintomi riconducibili alla Candida Auris sono infezioni del sangue, di ferite, otite o infezioni di organi addominali.
Cosa c’entra il cambiamento climatico con la Candida Auris
Ad alcuni potrà suonare strano, ma il riscaldamento globale ha una grande responsabilità nell’aumento di infezioni fungine di questo genere. L’innalzamento della temperatura globale, infatti, crea le condizioni favorevoli perché i funghi proliferino e si adattino al nostro organismo.
Questa “coincidenza” è provata dal fatto che 3 ceppi di Candida Auris sono comparsi nello stesso momento in 3 continenti diversi, particolarmente colpiti dal cambiamento climatico: America, Asia e Africa.
Quella della Candida Auris rimane quindi una situazione sicuramente da monitorare, ma ancora una volta l’uomo è causa del suo male.


